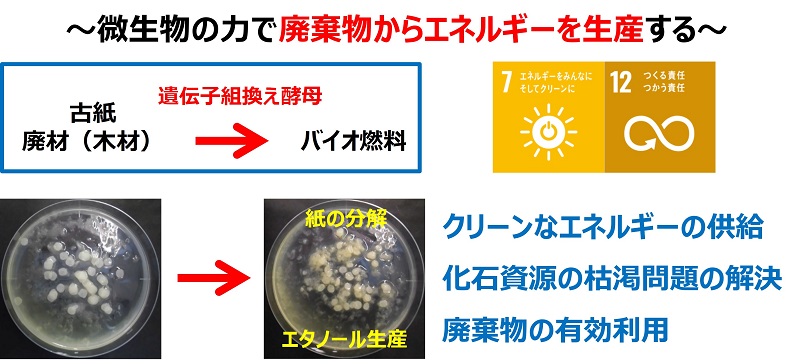

【生物工学科(生物科学科への名称変更 認可申請中)】オープンキャンパスで生き物を知る
8月20日(日)は福山大学オープンキャンパスです。大学では各学部学科がたくさんのイベントを企画していますが、生き物が好きならば、ぜひ生物工学科に来てみてください。ここでは、生物工学科で準備している内容を生物工学科のブログメンバーの佐藤が紹介します。
今回のオープンキャンパスでは、以下のように、DNAで動物の生態や進化を探る研究と、微生物を利用して暮らしを豊かにする研究の2つのテーマを準備しています。また、ラオス研修(2022年12月ブログ①、ブログ②、ブログ③、ブログ④)や、大学での学生の様子なども伝わればいいなと思っています。
テーマ①:動物の生態・進化(午前)
午前中はまず、DNAから生態系まで幅広いスケールで生き物を理解することを目指す学科の特徴を紹介します。また、ラオス研修、学生生活、卒業研究について学生が紹介します。
午前中のテーマは、動物の生態と進化です。生物多様性を理解するのに重要な学問である生態学と進化生物学の研究テーマについて紹介したいと思います。環境DNA技術を使った動物の生態の研究やDNA上に残された痕跡から動物の進化や退化を探る研究の最前線を紹介します。
午前中の1回目には、糞の中に含まれる生物のDNAを使って、動物の食性を解明する研究について紹介します。食性を分析することは、食物網を明らかにする第一歩となります。近年の遺伝分析技術のすさまじい発展により、動物たちの生態系における役割が見えてきました。特に里山環境でアカネズミが人の生活にどのような影響をもたらすのかを解説したいと思います。

午前中の2回目には、DNAに残された情報に基づいて、動物の進化と退化に関する研究を紹介します。特に、瀬戸内海の島に生息するアカネズミはどのように進化してきたのか?アザラシやアシカの味覚遺伝子が死んでいるとはどういうことか?など近年私たちが明らかにした哺乳類の進化に関する研究成果を紹介します。


テーマ②:微生物とDNA(午後)
午後には、微生物をテーマに教育・研究を紹介します。
微生物は、細菌、酵母、カビのような肉眼では観察できない小さな生物ですが、私達の暮らしに深く根付いています。パン、ヨーグルト、お酒は、微生物がいないとつくることはできないのです。現在、未発見のものも含め100万から1,000万種類以上の微生物がいると考えられています。微生物の機能は本当に多彩です。そうした多様な微生物の機能をもっと私たちの暮らしに利用できないでしょうか?
オープンキャンパスではまず、微生物の姿はどのようなものなのかを感じてもらいます。微生物の姿は顕微鏡で拡大して観察できます。細菌や酵母は単細胞生物で、いろんな形態のものがいます。カビは多細胞生物で植物のような複雑な姿をしています。植物の茎や花のような部分も見えます。目で直接見ることのできない世界をのぞいてみましょう。

微生物は、古代から食品や飲料の製造に利用されてきました。現在では、バイオテクノロジーの発展により、微生物を利用して私たちの生活はより一層豊かになっています。さらに、バイオ燃料やバイオプラスチックの生産などエネルギー問題や環境問題などの解決に利用され、SDGsやカーボンニュートラルの目標達成に大きく貢献しています。
その中で、わたしたちは、遺伝子組換え酵母を利用して、紙を分解してバイオ燃料を生産する研究を行っています。植物由来の廃棄物である古紙からのエネルギー生産でSDGsやカーボンニュートラルの目標達成に貢献することができるのです。オープンキャンパスでは、微生物の暮らしへの利用、遺伝子組換え酵母を利用した紙の分解の研究についてくわしく解説したいと思います。微生物を利用してより暮らしやすい社会を築いていきたいと考えています。
以上、簡単にではありますが、8月20日(日)のオープンキャンパスのイベントを紹介させていただきました。今回は40分区切りで、いろいろな学部学科をめぐることができます。ぜひ生物工学科にも気軽に足を延ばしてください。
福山大学は、そのユニークな教育舞台と充実した機器設備を使って、生物多様性の知識と技術を頭と体で学べる大学です。興味のある皆さんは、生物工学科(2024年4月より生物科学科に名称変更予定:文部科学省に認可申請中。一部内容を変更する場合があります。)で学んでみませんか?
学長から一言:来る8月20日(日)のオープンキャンパスでは、いろんな学科を自由に回れるスケジュールになっています。早くから志望先に決めていた学科や分野の他に、ちょっと覗いた学科で、案外その教育や研究内容に魅了されるかも知れません。生き物が大好きな人は生物工学科の催しに是非とも足を運んで頂きたいものです。きっと面白い出会いがあるはずです。




